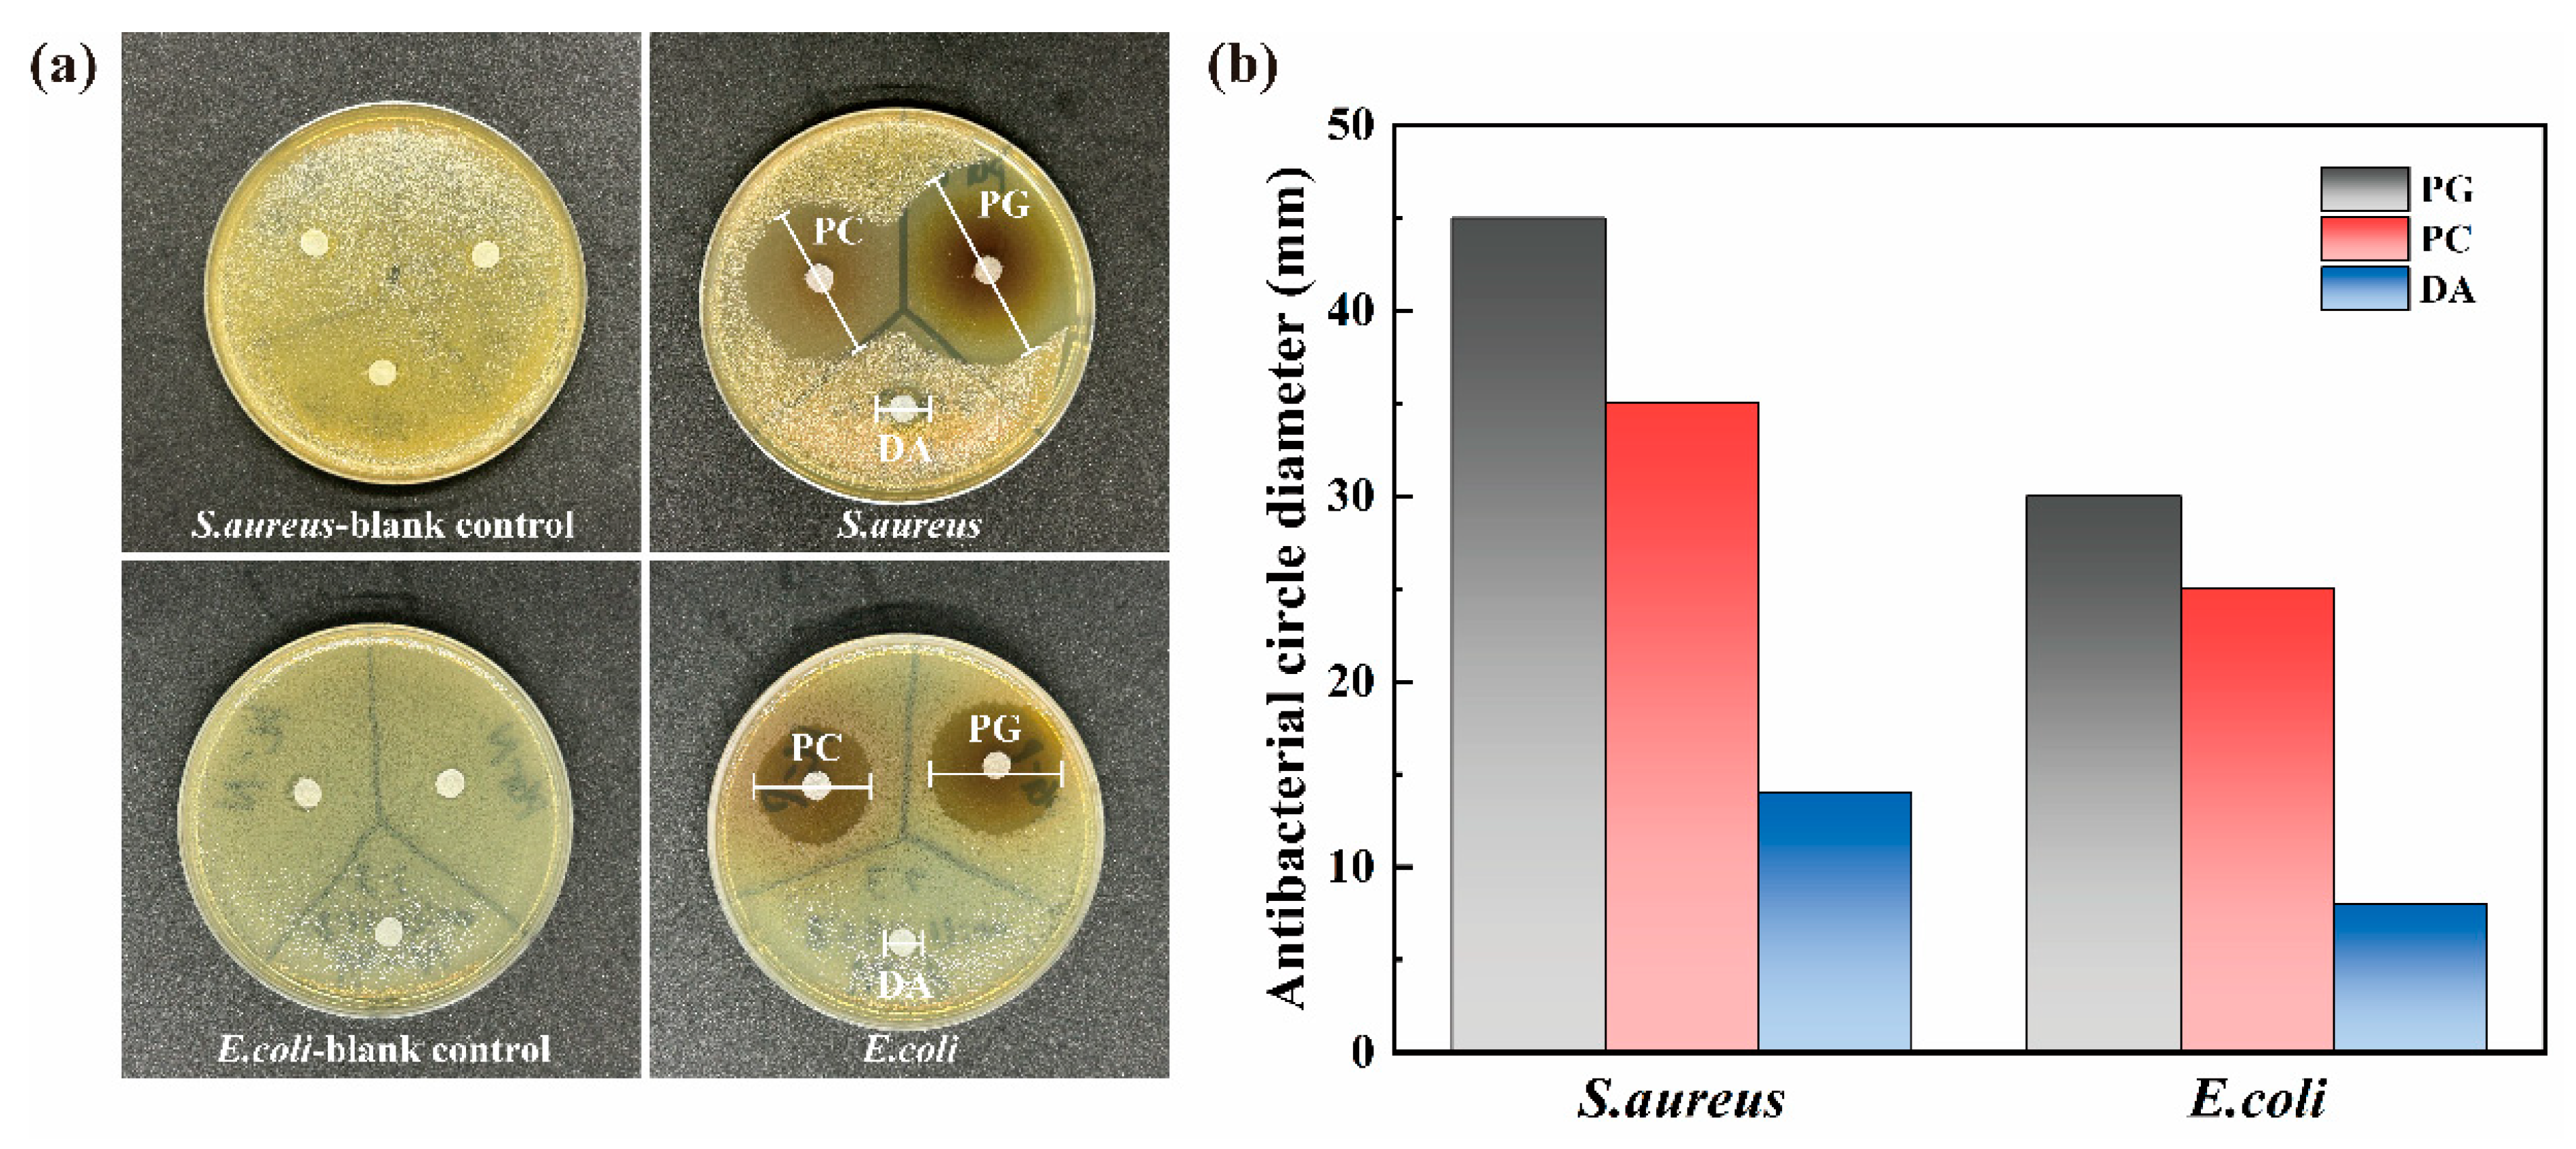
Jmse 13 00568 g006

Layer-by-Layer Self-Assembly Marine Antifouling Coating of Phenol Absorbed by Polyvinylpyrrolidone Anchored on Stainless Steel Surfaces
Abstract
1. Introduction
2. Materials and Methods
2.1. Materials
2.2. Fabrication of Layer-by-Layer (LbL)-Deposited Multilayer Coatings
2.3. Basic Characterization
2.4. Antifouling Performance Test
2.5. Characterization of Lubricating Properties
2.6. Micro-Scratch Test
3. Results and Discussion
3.1. Basic Characterization
3.1.1. FT-IR and XPS Characterization
3.1.2. Morphological Characterization
3.2. Antifouling Performance
3.3. Slippery Behavior
3.4. Scratch Testing Results
4. Conclusions
- (1)
- The three catechins PG, PC, and DA with the strongest antibacterial effect were selected for anchoring on the SS surface by the paper disc method. The results showed that PG had the strongest inhibitory effect on both the selected Gram-negative and Gram-positive bacteria.
- (2)
- For the three common marine fouling organisms, S. aureus, E. coli, and P. tricornutum, the SS-PG@PVP coating has an inhibition rate of 89.14%, 62.33%, and 82.13%, respectively. The introduction of PEI further improves the antifouling effect, and the inhibition rates are increased to 93.10%, 93.53%, and 95.40%, respectively.
- (3)
- The SS-PG@PVP coating and SS-PG@PVP/PEI coating both have a lower coefficient of friction under seawater immersion, 0.27 and 0.24, respectively, which is lower than the bare SS substrate under seawater immersion (0.38).
- (4)
- The results of the scratching tests demonstrated comparable behaviors across the three coatings. Initially, the AE signals remained stable due to the low modulus of the hydrogel. However, as the process of scratching progressed, there was an observed increase in the amplitude of the AE signals, with fluctuations occurring when the coating was fully removed. The adhesion strength was found to be 1.61 MPa, which increased to 2.02 MPa after PEI crosslinking. However, the coating thickness remained almost unchanged (12.650 μm to 12.670 μm), while the thickness of the two LbL coatings was 4.22 ± 0.03 μm.
Author Contributions
Funding
Data Availability Statement
Conflicts of Interest
References
- Zheng, N.; Jia, B.; Liu, J.; Wang, X.; Zhang, D.; Zhang, H.; Wang, G. Multi-strategy combined bionic coating for long-term robust protection against marine biofouling. J. Mater. Sci. Technol. 2025, 210, 265–277. [Google Scholar] [CrossRef]
- Liu, Z.; Zhao, H.; Jiang, T.; Qin, W. Influences of marine biofouling on the potential responses of polymeric membrane ion-selective electrodes. Sens. Actuators B Chem. 2025, 422, 136692. [Google Scholar] [CrossRef]
- Fragassa, C.; Mattiello, S.; Fronduti, M.; Del Gobbo, J.; Gagic, R.; Santulli, C. Prevention of biofouling due to water absorption of natural fiber composites in the aquatic environment: A critical review. J. Compos. Sci. 2024, 8, 532. [Google Scholar] [CrossRef]
- Jan, G.; Shafi, A.; Kirill, E.; Chun-lai, R.; Igal, S. Time Dependence of Lysozyme Adsorption on End-Grafted Polymer Layers of Variable Grafting Density and Length. Langmuir 2012, 25, 2122–2130. [Google Scholar]
- Schultz, M.P.; Bendick, J.A.; Holm, E.R.; Hertel, W.M. Economic impact of biofouling on a naval surface ship. Biofouling 2011, 27, 87–98. [Google Scholar] [CrossRef]
- Ali, A.; Culliton, D.; Fahad, S.; Ali, Z.; Kang, E.-T.; Xu, L. Nature-inspired anti-fouling strategies for combating marine biofouling. Prog. Org. Coat. 2024, 189, 108349. [Google Scholar] [CrossRef]
- Chen, T.L.; Lin, Y.P.; Chien, C.H.; Chen, Y.C.; Yang, Y.J.; Wang, W.L.; Chien, L.F.; Hsueh, H.Y. Fabrication of Frog-Skin-Inspired Slippery Antibiofouling Coatings Through Degradable Block Copolymer Wrinkling. Adv. Funct. Mater. 2021, 31, 2104173. [Google Scholar] [CrossRef]
- Chambers, L.; Wharton, J.; Wood, R.; Walsh, F.; Stokes, K. Techniques for the measurement of natural product incorporation into an antifouling coating. Prog. Org. Coat. 2014, 77, 473–484. [Google Scholar] [CrossRef]
- Salta, M.; Wharton, J.A.; Dennington, S.P.; Stoodley, P.; Stokes, K.R. Anti-biofilm performance of three natural products against initial bacterial attachment. Int. J. Mol. Sci. 2013, 14, 21757–21780. [Google Scholar] [CrossRef]
- Nehring, S. Long-term changes in Prosobranchia (Gastropoda) abundances on the German North Sea coast: The role of the anti-fouling biocide tributyltin. J. Sea Res. 2000, 43, 151–165. [Google Scholar] [CrossRef]
- Soroldoni, S.; Honscha, L.C.; Reis, F.O.; Duarte, F.A.; da Silva, F.M.R.; Pinho, G.L.L. Antifouling paint particles in soils: Toxic impact that goes beyond the aquatic environment. Ecotoxicology 2021, 30, 1161–1169. [Google Scholar] [CrossRef] [PubMed]
- Yu, W.; Koc, J.; Finlay, J.A.; Clarke, J.L.; Clare, A.S.; Rosenhahn, A. Layer-by-layer constructed hyaluronic acid/chitosan multilayers as antifouling and fouling-release coatings. Biointerphases 2019, 14, 051002. [Google Scholar] [CrossRef] [PubMed]
- Xu, G.; Pranantyo, D.; Xu, L.; Neoh, K.-G.; Kang, E.-T.; Teo, S.L.-M. Antifouling, antimicrobial, and antibiocorrosion multilayer coatings assembled by layer-by-layer deposition involving host–guest interaction. Ind. Eng. Chem. Res. 2016, 55, 10906–10915. [Google Scholar] [CrossRef]
- Li, S.; Huang, P.; Ye, Z.; Wang, Y.; Wang, W.; Kong, D.; Zhang, J.; Deng, L.; Dong, A. Layer-by-layer zwitterionic modification of diverse substrates with durable anti-corrosion and anti-fouling properties. J. Mater. Chem. B 2019, 7, 6024–6034. [Google Scholar] [CrossRef]
- Zhao, L.; Chen, R.; Lou, L.; Jing, X.; Liu, Q.; Liu, J.; Yu, J.; Liu, P.; Wang, J. Layer-by-Layer-Assembled antifouling films with surface microtopography inspired by Laminaria japonica. Appl. Surf. Sci. 2020, 511, 145564. [Google Scholar] [CrossRef]
- Nair, B. Final report on the safety assessment of polyvinylpyrrolidone (PVP). Int. J. Toxicol. 1998, 17 (Suppl. S4), 95–130. [Google Scholar] [CrossRef]
- Gultek, A.; Seckin, T.; Onal, Y.; Icduygu, M.G. Preparation and phenol captivating properties of polyvinylpyrrolidone-montmorillonite hybrid materials. J. Appl. Polym. Sci. 2001, 81, 512–519. [Google Scholar] [CrossRef]
- Nam, H.G.; Nam, M.G.; Yoo, P.J.; Kim, J.-H. Hydrogen bonding-based strongly adhesive coacervate hydrogels synthesized using poly (N-vinylpyrrolidone) and tannic acid. Soft Matter 2019, 15, 785–791. [Google Scholar] [CrossRef]
- Meng, H.; Li, Y.; Faust, M.; Konst, S.; Lee, B.P. Hydrogen peroxide generation and biocompatibility of hydrogel-bound mussel adhesive moiety. Acta Biomater. 2015, 17, 160–169. [Google Scholar] [CrossRef]
- McDonnell, G. The use of hydrogen peroxide for disinfection and sterilization applications. In PATAI’S Chemistry of Functional Groups; John Wiley & Sons: Hoboken, NJ, USA, 2009; pp. 1–34. [Google Scholar]
- Dogan, E.M.; Zalluhoglu, F.S.; Orbey, N. Effect of potassium ion on the stability and release rate of hydrogen peroxide encapsulated in silica hydrogels. AIChE J. 2017, 63, 409–417. [Google Scholar] [CrossRef]
- Munther, M.; Palma, T.; Angeron, I.A.; Salari, S.; Ghassemi, H.; Vasefi, M.; Beheshti, A.; Davami, K. Microfabricated biomimetic placoid scale-inspired surfaces for antifouling applications. Appl. Surf. Sci. 2018, 453, 166–172. [Google Scholar] [CrossRef]
- Wang, Y.; Jeon, E.J.; Lee, J.; Hwang, H.; Cho, S.; Lee, H. A phenol-amine superglue inspired by insect sclerotization process. Adv. Mater. 2020, 32, 2002118. [Google Scholar] [CrossRef] [PubMed]
- Liu, D.; Wang, H.; Dong, X.; Liu, X.; Dosta, S.; Zhang, C.; Cao, P. Enhancing antibacterial and anticorrosion properties of 304 stainless steel surfaces: A multi-modification approach based on DA/PEI/SiO2/AMPs. J. Coat. Technol. Res. 2023, 20, 979–994. [Google Scholar] [CrossRef]
- Wang, C.; Xiao, J.-K.; Xiao, S.-X.; Xu, G.-M.; Chen, J.; Zhang, C. Effect of Electrical Current on the Tribological Property of Cu-Graphite Brush. Tribol. Lett. 2024, 72, 29. [Google Scholar] [CrossRef]
- Johnson, K.L. Contact Mechanics; Cambridge University Press: Cambridge, UK, 1987. [Google Scholar]
- Oliver, W.C.; Pharr, G.M. An improved technique for determining hardness and elastic modulus using load and displacement sensing indentation experiments. J. Mater. Res. 1992, 7, 1564–1583. [Google Scholar] [CrossRef]
- Zhang, J.; Sun, T.; Hartmaier, A.; Yan, Y. Atomistic simulation of the influence of nanomachining-induced deformation on subsequent nanoindentation. Comput. Mater. Sci. 2012, 59, 14–21. [Google Scholar] [CrossRef]
- Elkins, J.; Marsh, J.L.; Lujan, T.; Peindl, R.; Kellam, J.; Anderson, D.D.; Lack, W. Motion predicts clinical callus formation: Construct-specific finite element analysis of supracondylar femoral fractures. J. Bone Jt. Surg. 2016, 98, 276–284. [Google Scholar] [CrossRef]
- Zhang, Q.; Wang, R.; Feng, B.; Zhong, X.; Ostrikov, K. Photoluminescence mechanism of carbon dots: Triggering high-color-purity red fluorescence emission through edge amino protonation. Nat. Commun. 2021, 12, 6856. [Google Scholar] [CrossRef]
- Katona, G.; Sipos, B.; Ambrus, R.; Csóka, I.; Szabó-Révész, P. Characterizing the drug-release enhancement effect of surfactants on megestrol-acetate-loaded granules. Pharmaceuticals 2022, 15, 113. [Google Scholar] [CrossRef]
- Muhammed, N.S.; Haq, B.; Al Shehri, D.; Al-Ahmed, A.; Rahman, M.M.; Zaman, E. A review on underground hydrogen storage: Insight into geological sites, influencing factors and future outlook. Energy Rep. 2022, 8, 461–499. [Google Scholar] [CrossRef]
- Karatas, H.; Townsend, E.C.; Cao, F.; Chen, Y.; Bernard, D.; Liu, L.; Lei, M.; Dou, Y.; Wang, S. High-affinity, small-molecule peptidomimetic inhibitors of MLL1/WDR5 protein–protein interaction. J. Am. Chem. Soc. 2013, 135, 669–682. [Google Scholar] [CrossRef]
- Xu, J.; Hou, Y.; Lian, Z.; Yu, Z.; Wang, Z.; Yu, H. Bio-inspired design of bi/tridirectionally anisotropic sliding superhydrophobic titanium alloy surfaces. Nanomaterials 2020, 10, 2140. [Google Scholar] [CrossRef] [PubMed]
- Oliveira, L.C.C.; Rodrigues, F.A.A.; Barbosa, C.R.d.S.; dos Santos, J.F.S.; Macêdo, N.S.; Silveira, Z.d.S.; Coutinho, H.D.M.; da Cunha, F.A.B. Antibacterial activity of the pyrogallol against Staphylococcus aureus evaluated by optical image. Biologics 2022, 2, 139–150. [Google Scholar] [CrossRef]
- Ni, N.; Choudhary, G.; Li, M.; Wang, B. Pyrogallol and its analogs can antagonize bacterial quorum sensing in Vibrio harveyi. Bioorg. Med. Chem. Lett. 2008, 18, 1567–1572. [Google Scholar] [CrossRef] [PubMed]
- Helander, I.M.; Alakomi, H.-L.; Latva-Kala, K.; Koski, P. Polyethyleneimine is an effective permeabilizer of gram-negative bacteria. Microbiology 1997, 143, 3193–3199. [Google Scholar] [CrossRef]
- Kang, X.; He, Y.; Lin, N.; Zhang, M.; Yan, Y.; Huang, J. A study of the preparation and properties of dense binderless titanium carbonitride-based ceramics. J. Alloys Compd. 2020, 843, 155941. [Google Scholar] [CrossRef]
- Yang, H.; Qin, L.; Zhao, W.; Mawignon, F.J.; Guo, H.; Wu, Y.; Zhang, Y.; Dong, G. Eco-friendly polysaccharide coatings for antifouling and drag-reduction and potential application for marine devices. Friction 2024, 12, 726–744. [Google Scholar] [CrossRef]
- Si, R.; Chen, Y.; Wang, D.; Yu, D.; Ding, Q.; Li, R.; Wu, C. Nanoarchitectonics for high adsorption capacity carboxymethyl cellulose nanofibrils-based adsorbents for efficient Cu2+ removal. Nanomaterials 2022, 12, 160. [Google Scholar] [CrossRef]
- Singla, A.; Singh, N.K.; Singh, Y.; Jangir, D.K. Micro and nano-crystalline diamond coatings of co-cemented tungsten carbide tools with their characterization. J. Bio-Tribo-Corros. 2021, 7, 35. [Google Scholar] [CrossRef]
- Kim, H.-K.; Kim, S.-M.; Lee, S.-Y. Mechanical properties and thermal stability of CrZrN/CrZrSiN multilayer coatings with different bilayer periods. Coatings 2022, 12, 1025. [Google Scholar] [CrossRef]

| Parameter | Value |
|---|---|
| Acquisition Rate/(Hz) | 30 |
| Begin Load/(mN) | 1000 |
| End Load/(mN) | 5000 |
| Loading Rate/(mN/min) | 19,600 |
| Speed/(mm/min) | 2 |
| Length/(mm) | 5 |
| Acoustic Emission Sensitivity | 9 |
| Material | Poisson Ratio | Young’s Modulus (MPa) | References |
|---|---|---|---|
| Diamond (ball indenter) | 0.07 | 1140 | [28] |
| SS 304 (substrate) | 0.3 | 210 | [29] |
| Calculated reduced Young’s modulus | N/A | 192.0776 | N/A |
| Samples | C (at%) | N (at%) | O (at%) |
|---|---|---|---|
| SS-PG@PVP | 47.81 | 9.57 | 42.63 |
| SS-PG@PVP/PEI | 45.75 | 10.77 | 43.48 |
| Samples | Average COF (Dry) | Average COF (Artificial Seawater Infiltration) |
|---|---|---|
| SS | 0.50 | 0.38 |
| SS-PG@PVP | 0.71 | 0.27 |
| SS-PG@PVP/PEI | 0.66 | 0.24 |
Disclaimer/Publisher’s Note: The statements, opinions and data contained in all publications are solely those of the individual author(s) and contributor(s) and not of MDPI and/or the editor(s). MDPI and/or the editor(s) disclaim responsibility for any injury to people or property resulting from any ideas, methods, instructions or products referred to in the content. |
© 2025 by the authors. Licensee MDPI, Basel, Switzerland. This article is an open access article distributed under the terms and conditions of the Creative Commons Attribution (CC BY) license (https://creativecommons.org/licenses/by/4.0/).
Share and Cite
Zheng, Z.; Wu, S.; Shu, H.; Han, Q.; Cao, P. Layer-by-Layer Self-Assembly Marine Antifouling Coating of Phenol Absorbed by Polyvinylpyrrolidone Anchored on Stainless Steel Surfaces. J. Mar. Sci. Eng. 2025, 13, 568. https://doi.org/10.3390/jmse13030568
Zheng Z, Wu S, Shu H, Han Q, Cao P. Layer-by-Layer Self-Assembly Marine Antifouling Coating of Phenol Absorbed by Polyvinylpyrrolidone Anchored on Stainless Steel Surfaces. Journal of Marine Science and Engineering. 2025; 13(3):568. https://doi.org/10.3390/jmse13030568
Chicago/Turabian StyleZheng, Zaixiang, Shutong Wu, Haobo Shu, Qingzhen Han, and Pan Cao. 2025. "Layer-by-Layer Self-Assembly Marine Antifouling Coating of Phenol Absorbed by Polyvinylpyrrolidone Anchored on Stainless Steel Surfaces" Journal of Marine Science and Engineering 13, no. 3: 568. https://doi.org/10.3390/jmse13030568
APA StyleZheng, Z., Wu, S., Shu, H., Han, Q., & Cao, P. (2025). Layer-by-Layer Self-Assembly Marine Antifouling Coating of Phenol Absorbed by Polyvinylpyrrolidone Anchored on Stainless Steel Surfaces. Journal of Marine Science and Engineering, 13(3), 568. https://doi.org/10.3390/jmse13030568
